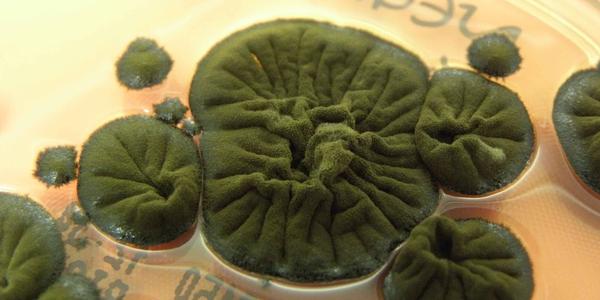

Телевизор Harper 43F720T: сбалансированный выбор для домашнего кинотеатра
Выбор телевизора для дома - задача не из простых, учитывая многообразие моделей на рынке. Harper 43F720T — одна из таких моделей, которая вполне заслуживает внимания. В обзоре мы рассмотрим основные функции и дизайн этой модели, а также я поделюсь с вами результатами моих тестов. Надеюсь, что эта статья предоставит объективный взгляд на Harper 43F720T и поможет определить, насколько модель телевизора, без таких функций, как SmartTV подходит для ваших потребностей в домашнем развлечении.
Технические характеристики Harper 43F720T
- Диагональ экрана: 43 дюйма
- Разрешение экрана: 1920х1080 (Full HD)
- Тип панели: VA
- Частота обновления экрана: 60 Гц
- Время отклика пикселя: 8 мс
- Яркость: 250 Кд/м²
- Контрастность: 90000:1
- Количество цветов: 16,7 млн
- Углы обзора: 178°
- Акустическая система: Встроенная акустика 16 Вт (2x8 Вт)
- Поддержка видеоформатов/кодеков: MPEG2, MPEG4, AVI, Xvid, MOV, VOB, MKV
- Поддержка аудиоформатов/кодеков: AC3, MP3, M4A
- Поддержка форматов изображений: JPEG, BMP, PNG
- Разъемы и интерфейсы: 2 HDMI порта (версия 1.4), 1 USB 2.0 порт, антенный вход, цифровой аудио выход, разъем для наушников (jack 3,5), поддержка CI
- Дополнительные функции: Телетекст (1000 стр.), запись ТВ программ, электронный Телегид, функция Time Shift, 3D фильтр шума
- Крепление: Стандарт Vesa 200х100 мм
- Материал корпуса: Пластик
Упаковка и комплект поставки
Телевизор Harper 43F720T поставляется в коробке из переработанного картона. Коробка малоинформативна, содержит на себе информацию о наименовании модели и диагонали устройства.
Внутри коробки расположились четыре ложемента из пенопласта, которые надежно фиксируют корпус телевизора внутри коробки.
Комплект поставки достаточно неплохой и включает все необходимое для начала работы с устройством, прямо из коробки:
- Телевизор Harper 43F720T;
- Две опорные подставки;
- Винты крепления подставки;
- Кабель питания;
- Пульт дистанционного управления;
- Две батарейки ААА;
- Инструкция по эксплуатации и гарантийный талон.
Внешний вид
Большую часть передней панели телевизора занимает экран. Тонкие черные каемки по краям экрана создают впечатление безрамочности. Внизу находится единственная видимая рамка с надписью «Harper», которая расположилась по центру.
Задняя часть изготовлена из матового черного пластика, что придает телевизору современный и стильный вид. Она несколько выпуклая, что обычно для телевизоров данного типа. Телевизор поддерживает стандарт крепления VESA 200х200, что позволяет удобно монтировать его на стену.
Порты и интерфейсы расположены на боковых сторонах, что облегчает подключение внешних устройств и не мешает при настенном монтаже. На задней панели нашлось место под антенный вход, два разъема HDMI версии 1.4, разъем USB 2.0, цифровой аудио выход, разъем для наушников jack 3.5 и слот CI. Основная масса портов выходит на левую сторону.
На нижней части расположены решетки динамиков и охлаждения, а также пазы для подставок. Подставки выполнены из черного пластика и не выходят за пределы телевизора, по бокам, обеспечивая устойчивость.
Таким образом, Harper 43F720T сочетает в себе современный дизайн с практичным расположением портов и удобным креплением, делая его подходящим для различных интерьеров.
Функциональные особенности
Нельзя сказать, что телевизор Harper 43F720T впечатляет своими функциональными особенностями, но при этом важно отметить, что он обладает весьма неплохими техническими характеристиками. Рассматриваемая модель имеет экран 43-дюймовый с Full HD разрешением (1920х1080@60), что обеспечивает вполне достойное качество изображения. Матрица VA с частотой обновления 60 Гц способна обеспечить нас качественной, плавной картинкой. Углы обзора 178° позволяют комфортно просматривать изображение с любого места в комнате, при этом инверсии цветов практически не наблюдается.
Телевизор Harper 43F720T имеет контрастность 90000:1, что обеспечивает глубокие черные и яркие белые цвета, делая изображение более насыщенным и реалистичным. Время отклика пикселя составляет 8 мс, что гарантирует достаточную плавность движения в динамичных сценах, таких как спортивные мероприятия или быстрые сцены в фильмах и играх.
В звуковой части телевизор не уступает большинству аналогов от именитых брендов. 16 Вт мощности с эквалайзером обеспечивают качественное аудио. Поддержка различных мультимедийных форматов и возможность воспроизведения с внешних носителей делают его практически универсальным вариантом для просмотра любимого контента.
Хотя в нем нет доступа к смарт-функциям и интернету, Harper 43F720T компенсирует это возможностью подключения внешних источников через HDMI и USB порты, которые позволяют подключать различные устройства и расширять возможности просмотра. Также в арсенале устройства имеется аудиовыход, разъем для наушников, и плюс ко всему, есть такие функции, как телетекст, запись программ, Time Shift.
Тестирование
Тестирование качества изображения разделилось на два этапа. Для начала на устройстве запускался контент различного вида (спортивные соревнования, динамические фильмы, музыкальные клипы, новостные передачи). Весь контент просматривался в HD-качестве. Яркость, контрастность и цветопередача экрана находилась на приличном уровне. Зернистость изображения, при близком просмотре наблюдается, но это вполне ожидаемо, поскольку устройство оснащено учитывая четкость изображения и насыщенность цветов на экране VA с Full HD разрешением.
Углы обзора — хорошие. Инверсии цветов практически не наблюдается.
Далее, чтобы визуализировать результаты, устройство подверглось тестированию с использованием калибратора мониторов. С помощью этого устройства можно наглядно увидеть возможности матрицы.
Результаты тестирования показывают, что матрица имеет весьма неплохое покрытие и объем цветового диапазона. Для бюджетного телевизора показатели можно назвать отличными.
Также качество матрицы оценивалось с использованием OPPLE Light Master IV. В целом это прибор для определения качества освещения, но оценить частоту мерцания матрицы он способен.
Подключение различных устройств через HDMI и USB порты продемонстрировало могло бы демонстрировать их удобство и функциональность. Впечатления, возможно, были бы смешанными, в зависимости от гибкости интерфейсов и поддерживаемых форматов. В моем арсенале нашлась флеш-карта объемом 512 ГБ, отформатированная в файловой системе NTFS. Никаких сложностей со чтением файлов у меня не возникло.
Прослушивание музыкальных треков различных жанров и звуковых дорожек фильмов показало достаточно среднее качество звучания, что не удивительно, для телевизора данной ценовой группы. Качество звучания встроенных динамиков можно назвать вполне достойным. Звук оказался громким, но средних и низких частот в звучании не хватает. Динамики телевизора не хрипели даже на максимальных настройках громкости. Звук сложно назвать объемным, но в целом звучание вполне приемлемо.
Комплектный пульт дистанционного управления имеет в меру крупные габаритные размеры и обширный набор функциональных клавиш, которые обеспечивают быструю и удобную навигацию по меню. Пользовательский интерфейс удобный и интуитивно-понятный, хотя, управляя медиаплеером я не сразу понял, что запуск воспроизведения контента осуществляется кнопками в нижней части пульта, а не кнопкой «Ок», как в большинстве случаев.
Заключение
Качество изображения телевизора Harper 43F720T делает его хорошим выбором для просмотра фильмов и спортивных программ. С его Full HD разрешением и VA панелью, телевизор предлагает четкое и яркое изображение с хорошей цветопередачей. Это обеспечивает достойный просмотр как кино, так и динамичных спортивных трансляций. Что касается использования устройства с современными игровыми консолями, Harper 43F720T вполне справится с этой задачей. Однако для полного погружения в игровой процесс и использования всех возможностей последних версий консолей лучше рассмотреть модели с 4K матрицей и более высокой частотой обновления. Это обеспечит более детализированное изображение и плавность движения, что особенно важно в современных играх. Качество звучания — хорошее. Встроенные динамики способны наполнить небольшую комнату хорошим звучанием, которого с лихвой хватит для комфортного просмотра спортивных трансляций, фильмов либо музыкальных клипов. Несмотря на отсутствие Smart функций и подключения к интернету, Harper 43F720T оставляет приятные впечатления и может быть хорошим выбором для тех, кто ищет базовый, но качественный телевизор. Он хорошо подходит для просмотра традиционных ТВ-каналов, фильмов и игр.
PS:
В добавлении к этому хочу сказать, что телевизор планируется вешать на стене. Для этих целей будет использован кронштейн Harper TVFW-42, который, кажется, станет отличным выбором. У него есть несколько крутых характеристик. Во-первых, он подходит для телевизоров с диагональю от 13 до 43 дюймов и весом до 20 кг. Так что, под этот телевизор кронштейн вполне подойдет. Особенно удобно то, что он поддерживает разные стандарты VESA — от 75x75 до 200x200 мм. Так что, вне зависимости от модели телевизора, есть возможность его установки.
TVFW-42 позволяет изменять положение телевизора, так, что, я смогу осуществлять просмотр со всех уголков комнаты, ведь угол наклона у него достаточно широк — от -12 до +5 градусов.
И еще важный момент — крепление кронштейна. Он позволяет тесно прилегать к стене, что добавляет аккуратности интерьеру. Расстояние от стены может быть настроено от 50 до 275 мм, так что у есть возможность регулировать, насколько близко телевизор будет к стене.
Узнать актуальную стоимость Harper 43F720T можно перейдя по ссылке, кронштейн Harper TVFW-42 находится здесь.

44 комментария
Добавить комментарий
Дальше можно не читать.
Ясно, понятно. Кликбейтный заголовок, чтобы отработать заказ и потихоньку слиться в комментах…
«Никаких сложностей со чтением файлов у меня не возникло.» — особенно вот это забавно. «Поддержка видеоформатов/кодеков» смешались в кучу люди, кони…
Вы свои заголовки сами не читаете?
Вам камрад вполне резонно указал на, мягко говоря, попытку «введение в заблуждение» читателей уважаемого ресурса.
Прежде чем что то откровенно «впаривать», потрудитесь хоть немного поизучать тему.
Например, упомянутого Вами в кликбэйте «домашнего кинотеатра».
И еще, раз уж вы такой ценитель остроумия, было бы здорово, если бы вы поделились своими знаниями по теме. Вместо того чтобы оставлять замечания 'по поверхности', почему бы не углубиться и не дать конструктивный комментарий? Ведь обмен мнениями должен обогащать, а не превращать чат в барахолку словесных игр.
Добавить комментарий